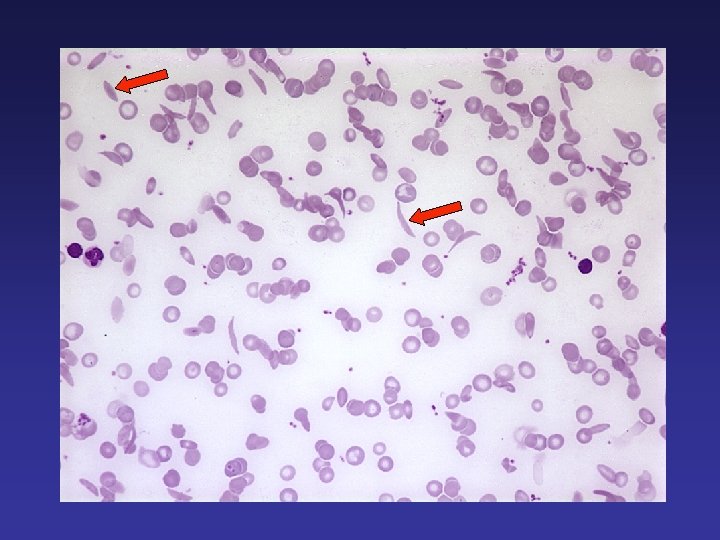
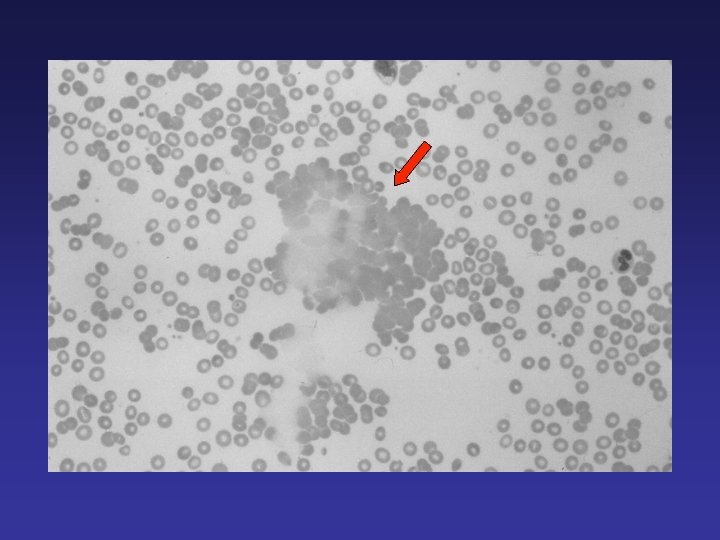

Hematology for Surgeons Michael H Rosove MD Clinical

- Slides: 27
Hematology for Surgeons Michael H. Rosove, MD Clinical Professor of Medicine UCLA Division of Hematology-Oncology November 13, 2013
Anemias Abrupt post-op drop in Hgb ― post-op equilibration, acute bleeding, or hemolysis Sickle cell disorders Thrombotic microangiopathies Autoimmune and alloimmune hemolysis Miscellaneous hemolytic anemias ― sepsis (especially Clostridium perfringens), liver disease, shear-related
Anemias Sickle (Hgb S) disorders Hgb SS > SC and S-β thalassemia > AS Severity lessened by α-thalassemia minor, elevated Hgb F (hereditary persistence or hydroxyurea) Problems: small vessel thrombotic occlusion (bone pain crisis, in situ pulmonary infarction, ischemic stroke, splenic or renal infarction), ↑ VTE risk Management: avoid dehydration and hypoxemia, preop transfusion (to raise % Hgb A) in severe cases, VTE prophylaxis in appropriate settings
Anemias Thrombotic microangiopathies (TMAs) Precapillary microvascular thrombosis, red cell fragmentation, thrombocytopenia, end-organ dysfunction/damage TMA may follow organ transplantation ― especially kidney, lung, and allogeneic marrow stem cell transplantation Target organ: Predominantly kidneys Predisposing factors: Allograft rejection, infections, combined calcineurin and m. TOR inhibitor therapies Plasma exchange not known to be effective ? role for eculizumab (C 5 inhibitor)
Anemias Autoimmune hemolysis Causes: drugs, infections Spherocytosis (+ agglutination), DAT+, Ig. G + C 3, antibody screen or RBC eluate shows non-specific warm auto Treatment: Dependent on cause and severity Alloimmune hemolysis Causes: “Major hemolytic” transfusion reaction “Delayed hemolytic” transfusion reaction IV Ig Liver transplant ― recipient has an RBC antigen the allograft lacks Spherocytosis (+ agglutination), DAT+, antibody screen or RBC eluate shows antigen specificity Treatment: Dependent on cause and severity
Anemias Jehovah’s Witness Determine which blood component(s) the patient will accept, including Cell. Saver blood Be sure the patient understands the risks of refusing blood products Ask the hardest question and document ― “If your life depended on a blood transfusion, would you prefer to die or to receive transfusion? ” Have the patient and spouse or next of kin (who may have minor dependents) release the physicians and hospital from responsibility for an adverse outcome due to refusal of blood products Treatment options: Iron, erythropoietin, oxygen, non-blood product treatment of coagulopathy
Coagulopathies Tests: Protime (INR), PTT, fibrinogen, D-dimers, occasionally factor level(s), ? bleeding time Only a few causes of isolated prolonged PT: Mild vitamin K deficiency or warfarin effect Mild liver dysfunction Mild DIC Congenital factor VII deficiency (any severity) Mild common coagulation pathway deficiencies (congenital deficiency of factor X, V, II, or fibrinogen)
Coagulopathies Only a few causes of isolated prolonged PTT: Mild liver dysfunction UFH, LMWH, fondaparinux, bivalirudin Congenital deficiency of VIII (including VWF), IX, XII, prekallikrein, HMW kininogen) Lupus anticoagulant (common) Acquired factor VIII inhibitor (rare)
Coagulopathies Clinical consequences depend on cause of prolonged PTT! Cause PTT Consequence Factor VIII inhibitor 50 sec. Major spontaneous bleeding Severe XII deficiency disorder 120 sec Not a bleeding (factor XII 1%) Mild von Willebrand disease 35 sec. Surgical bleeding (factor VIII and VWF 40%) Lupus anticoagulant 45 sec. Thrombotic tendency
Coagulopathies Only a few causes of combined prolonged PT/PTT: Dilutional coagulopathy (during exsanguination or plasmapheresis) DIC / fibrinolysis Severe liver dysfunction Anticoagulants Congenital deficiency (factor X, V, V/VIII, fibrinogen) Acquired factor V inhibitor (topical bovine thrombin) Acquired factor X deficiency (primary amyloidosis)
Coagulopathies Only a few causes of hypofibrinogenemia: Dilutional coagulopathy (exsanguination, plasmapheresis) DIC / fibrinolysis Severe liver dysfunction Congenital
Coagulopathies Bleeding disorders with normal PT, PTT, fibrinogen: Thrombocytopenia and platelet dysfunction von Willebrand disease (common) mild hemophilia (VIII or IX) carrier state in women factor XIII deficiency (very rare)
Available treatments for bleeding disorders FFP ― all clotting factors Cryoprecipitate ― fibrinogen, VWF, VIII Concentrates ― VIII, VWF, IX (including “ 4 -factor concentrates”), XIII Recombinant VIIa ― for factor VIII or IX inhibitors, congenital factor VII deficiency FEIBA (factor VIII inhibitor bypassing activity) Vitamin K ― to prevent/correct deficiency, reverse warfarin DDAVP (desmopressin) ― raises factor VIII/VWF levels Aminocaproic and tranexamic acid ― mild fibrinolytic inhibition High-dose conjugated estrogens ― multiple effects Protamine sulfate ― reverses UFH well and LMWH somewhat TPO receptor agonists ― may raise platelet count
Initial approach to the exsanguinating patient Identify the site of bleeding, and target it for attention Establish enough large-gauge venous accesses Aggressive volume resuscitation to avoid shock state Avoid pressors if possible RBC transfusion Blood products to avoid dilutional coagulopathy FFP cryoprecipitate platelet transfusion If bleeding is diffuse oozing and refractory, then consider some combination of a fibrinolytic inhibitor and highdose conjugated estrogens
Indications/risks of transfusing blood products RBC indications: “severe” or symptomatic anemia, especially with ongoing bleeding or hemolysis Platelet (single- or multiple-donor) indications: <100, 000 with serious active bleeding <75, 000 with upcoming invasive intervention <20, 000 with sepsis or other bleeding liabilities <10, 000 Volume overload Alloimmunization; cross-matching difficulties and resulting delays Hepatitis C and HIV, other infections Allergic reactions
Thrombophilia testing d. RVVT ― anticoagulants may produce “borderline” results Cardiolipin and beta 2 -glycoprotein I antibodies ― always valid ATIII ― GAG anticoagulants and DIC consume it PS ― half bound to C 4 b. BP, an acute phase reactant; order total Ag, not activity PS, PC, ATIII ― all reduced if liver dysfunction present VIII ― an acute phase reactant Factor V Leiden and prothrombin G 20210 A ― invalid in OLT and BMT pts; APCR (activated protein C resistance ratio) is valid, factor II (prothrombin) is valid if protime is normal
The anticoagulants Glycosaminoglycans (GAGs) ― UFH, LMWH (e. g. , enoxaparin), fondaparinux Vitamin K antagonist ― warfarin Parenteral anti-thrombins ― argatroban (Argatroban), bivalirudin (Angiomax) Oral anti-thrombin ― dabigatran (Pradaxa) Oral anti-Xa’s ― rivaroxaban (Xarelto), apixaban (Eliquis)
Glycosaminoglycan Anticoagulants heparin (UFH) Source Porcine/bovine Mean # saccharides 36 Action ATIII, IIa>Xa Plasma protein binding +++ Bioavailability Variable Half-life, hr Variable, ~6 (SQ) <1 -3 (IV) PF 4 binding ++ GAG/PF 4 antibodies ++ HIT 1%-3% Effect of renal dysfunction ++ Monitoring PTT Protamine as antidote ++ Pregnancy category C LMWH Altered UFH 13 ATIII, Xa>IIa + 90% ~6 (SQ) Fondaparinux Synthetic 5 ATIII, Xa + 100% ~17 (SQ) ++ ++ 0. 3%-0. 8% ++ Anti-Xa + B ++ ++ Almost never ++ Anti-Xa – B
Heparin-induced thrombocytopenia HIT remains primarily a clinical diagnosis! Platelet count falls between d. 4 -14 of de novo therapy by 50% of greater Consider other causes of thrombocytopenia Heparin-PF 4 EIA usually strongly positive, almost never negative, Ig. G-only assays improve specificity; SRA more specific but time-consuming, expensive Thrombosis (anywhere) occurs in about 30% of cases, may be multifocal, often devastating, often litigates Platelet count usually recovers quickly Patients remain hypercoagulable for about 2 wks Argatroban dosage is reduced for hepatic insufficiency Bivalirudin dosage is reduced for renal insufficiency
The newer anticoagulants Acute AF HIT VTE Argatroban * Bivalirudin * Ortho VTE proph ACS * Dabigatran * * * Rivaroxaban * * * Apixaban * = FDA approved indication * = non-FDA approved indication * *
GAGs and VKAs — Still Important Cardiopulmonary bypass: UFH Prosthetic heart valves: VKA Chronic valvular AF: VKA Chronic non-valvular AF: VKA still acceptable if TTR very good and/or patient can’t afford a new anticoagulant Hypercoagulability of malignancy: GAGs Antiphospholipid syndrome: VKA Non-orthopedic med/surg VTE prophylaxis: GAGs or VKA Pregnancy: GAGs Breast feeding: GAGs or VKA Advanced renal failure: UFH, VKA Morbid obesity: GAGs, VKA